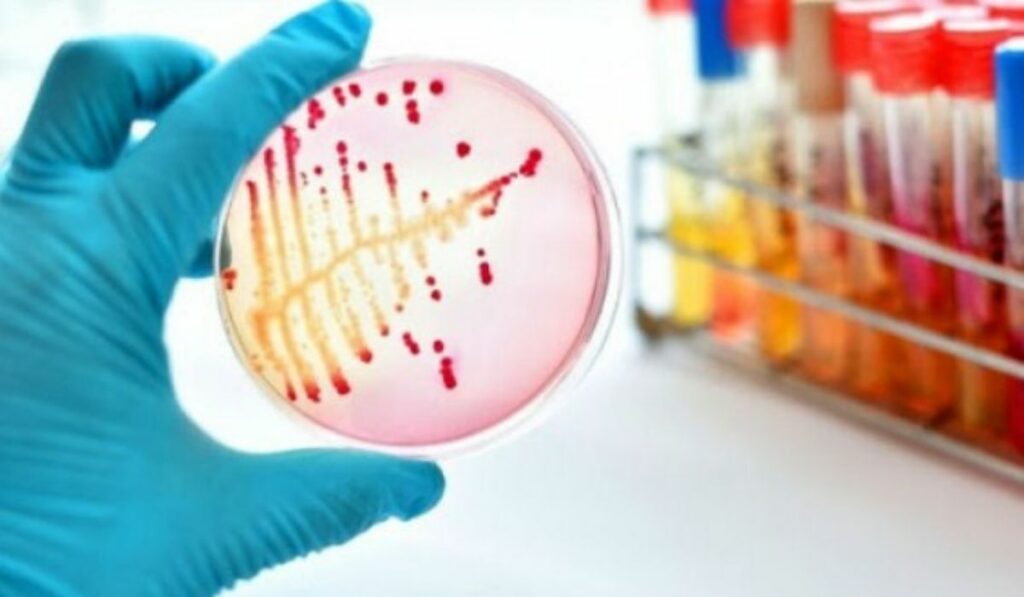

Ya hacía varias semana Uruguay confirmaba un caso por infección del hongo negro ahora le tocó a Argentina donde una persona murió. El Centro de Micología de la Facultad de Medicina de la Universidad de Buenos Aires confirmo este hecho. Al parecer un común denominador en todos los casos tiene que ver con la diabetes y el covid-19.
Una persona muere por infección del hongo negro o mucormicosis en Argentina
Se trata de una persona de 35 años y que tenía además de un cuadro de covid-19, diabetes. Se le diagnosticó una diabetes no tratada y recién acaba de salir del coronavirus señalo el centro micológico. Adicionalmente, la victima estuvo bajo hospitalización en Lomas de Zamora una clínica de Buenos Aires según autoridades.
Una experta que está adscrita al Centro de micología Lujan Cuestas dijo “El debilitamiento de nuestras defensas que deja el covid-19 hace que cualquier infección o enfermedad sea razón primordial para alojarse al cuerpo”. Esta experta también pertenece al Consejo Nacional de Investigaciones Científicas y Técnicas – Conicet y destacó una investigación al respecto.
Investigación señala que las defensas bajas de la persona es clave
Lujan Cuestas hizo referencia a una investigación que da muestras de la mucormicosis en varios casos que suele detectarse muy tarde. “Los diabéticos no controlados, los pacientes tratados con dosis altas de corticoides y las personas que tengan defensas a niveles bajos son más propensas a contraer el hongo negro, es difícil de tratar y se suele detectar de manera tardía”, dijo la investigadora en este aspecto.
También agregó que “la evolución es muy brusca y fatal”, nada alentador pues señala que el 95% de los casos se llega a la muerte. En el ámbito latinoamericano, ya son varios los países que han confirmado casos de hongo negro. Los países ya confirmados son Uruguay, Chile, Brasil y México lo que pone en alerta a la región que ya viene azotada por la pandemia.
Esta mucormicosis u hongo negro tiene más incidencia en la India donde expertos señalan que son varias causas. Una de ellas es que viene por mala manipulación de abonos orgánicos pues proviene de estos contextos. Otra variable puede ser la mala higiene y lo que causa más terror es que ataca la cara directamente.
Así se contrae la infección del hongo negro
Esta infección es causada por los ambientes húmedos como el compost y la tierra, donde frecuentemente se localiza este moho. Al contagiarse no es posible que ocurra lo mismo de persona a persona y ataca en primera instancia a la cara y vías respiratorias. Las vías de transmisión son, los senos nasales, la nariz, los ojos y puede ocasionar daños cerebrales.
En la India en la mayoría de los casos las personas tenían diabetes y muchas ni siquiera sabían que tenía esta enfermedad. Puede incluso dañar los pulmones y varias partes del cuerpo como el estómago, piel conociéndose así la mucormicosis gástrica y cutánea respectivamente.